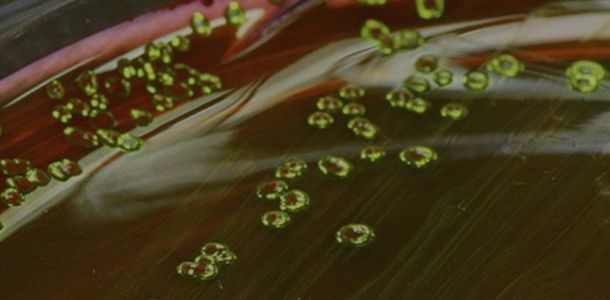

Especialidad Médica en Anatomía Patológica
Especialidad Médica Acreditada 6 años, hasta el 11 de septiembre de 2030. Comisión Nacional de Acreditación, CNA Chile.

Especialidad Médica en Anestesiología y Reanimación
Especialidad Médica Acreditada por 7 años, hasta 11 de octubre de 2030. Comisión Nacional de Acreditación.

Especialidad Médica en Cardiología
Especialidad Médica Acreditada por 7 años, hasta 11 de octubre de 2030. Comisión Nacional de Acreditación.


Especialidad Médica en Cirugía General
Especialidad Médica Acreditada por 5 años, hasta 24 de enero de 2029. Comisión Nacional de Acreditación, CNA Chile.

Especialidad Médica en Cirugía Pediátrica
Especialidad Médica Acreditada 7 años, hasta 22 de agosto de 2025. Agencia Nacional de Acreditación.

Especialidad Médica en Medicina Familiar
Especialidad Médica Acreditada por 5 años, hasta 24 enero de 2029. Comisión Nacional de Acreditación, CNA Chile.


Especialidad Médica en Neonatología
Especialidad Médica Acreditada por 5 años, hasta el 5 de junio de 2029. Comisión Nacional de Acreditación, CNA Chile.


Especialidad Médica en Neurología Adulto
Especialidad Médica Acreditada 6 años, hasta 20 de marzo de 2030, Comisión Nacional de Acreditación CNA, Chile.

Especialidad Médica en Neuropediatría
Especialidad Acreditada por 6 años, hasta 20 de diciembre de 2029. Comisión Nacional de Acreditación CNA Chile.


Especialidad Médica en Neurorradiología Diagnóstica Intervencional
En proceso de acreditación.


Especialidad Médica en Oftalmología
Especialidad Médica Acreditada por 7 años, hasta 16 de noviembre de 2030. Comisión Nacional de Acreditación CNA Chile.





Especialidad Médica en Psiquiatría Infantil y de la Adolescencia
Especialidad Médica Acreditada 5 años, hasta el 23 de enero de 2030. Comisión Nacional de Acreditación, CNA Chile.




Registro de interés de Postgrado y Postítulo
Selecione el programa de su interés y complete los datos solicitados.